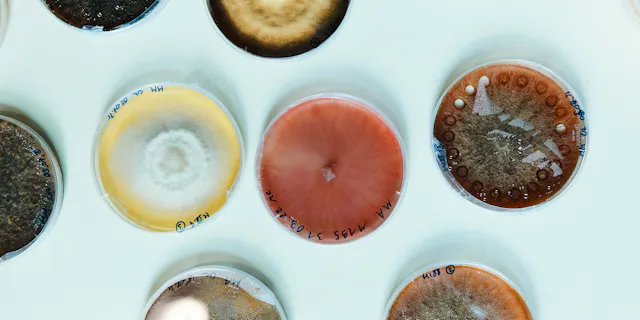

Plattformen für Produktivität
Interview mit Fiona Marshall, President of Biomedical Research bei Novartis.

Gemeinsam sind wir stärker
Teamgeist.

Die Kraft der Kooperation und der Kommunikation
Reden ist gold.

Stärkung der Widerstandskraft
Editorial von Steffen Lang für Live N°13.

Wissenschaft, Zufälle und ein Gespür für die Bedürfnisse der Patienten
Ein Gespräch mit Shiva Malek.

Innovationen erfordern Mut
Editorial von Jörg Reinhardt für Live N°12.

Kollektive Stärke
Zusammenführung von Wissenschaft und Industrie.
Mut und Zusammenarbeit
Editorial von Jörg Reinhardt.

«Wir suchen den Austausch mit der Bevölkerung»
Jörg Reinhardt im Gespräch.

Eine Plattform für den intellektuellen Austausch
Editorial von Matthias Leuenberger.

Innovation und Zusammenarbeit
Editorial von Matthias Leuenberger für live 11.

Das Richtige tun
Fehler müssen behoben werden.

Mut und Zuversicht
Editorial von Jörg Reinhardt.

«Wir müssen die Patienten ins Zentrum unserer Umweltanstrengungen rücken»
Ein holistischer Umweltansatz.

«Wir müssen die Schwellenländer in den Innovationszyklus einbeziehen»
Zugang entwickeln.

«Wir müssen uns bei der Bekämpfung des Klimawandels hohe Ziele setzen»
Know-how aus dem Pentagon.

Begeisterung für Daten
1:1 mit Chief Digital Officer Bertrand Bodson.
Shorts
Unsere Geschichten in Kurzform

Frühere Ausgaben durchblättern
Zugang zu den Printausgaben des live -Magazins
Laden Sie vergangene Ausgaben als PDF-Datei herunter.
Über Live.Magazine
Live.Magazine ist seit 1996 die interne Publikation von Novartis, wurde 2015 zu einem globalen Feature-Magazin und erschien 2020 erstmals in digitaler Form.
Es erscheint in vier Sprachen: Englisch, Deutsch, Chinesisch und Japanisch. Pro Jahr werden vier englische und zwei deutsche Druckausgaben veröffentlicht, jeweils ergänzt durch das Supplement „Forum“.
Learn more
Über live Magazin
Das live Magazin ist seit 1996 das in-house Magazin von Novartis. Seit 2020 ist es öffentlich zugänglich.
Mitarbeitende/Pensionäre
Mitarbeitende in der Schweiz und RentnerInnen können die Forum-Beilage mit Geburtstagen und weiteren Daten per E-Mail erhalten. Bitte schreiben Sie an live.magazine@novartis.com unter Angabe Ihres Namens und Ihrer Personalnummer.
Bleiben Sie auf dem Laufenden
Bleiben Sie auf dem Laufenden, indem Sie unseren Newsletter abonnieren.
Mit dem Absenden Ihrer E-Mail erklären Sie sich damit einverstanden, dass die Novartis AG Ihre E-Mail-Daten für den internen Gebrauch von Novartis, in Übereinstimmung mit unserer Datenschutzrichtlinie und mit geschützten technischen Mitteln erfasst und verarbeitet.













